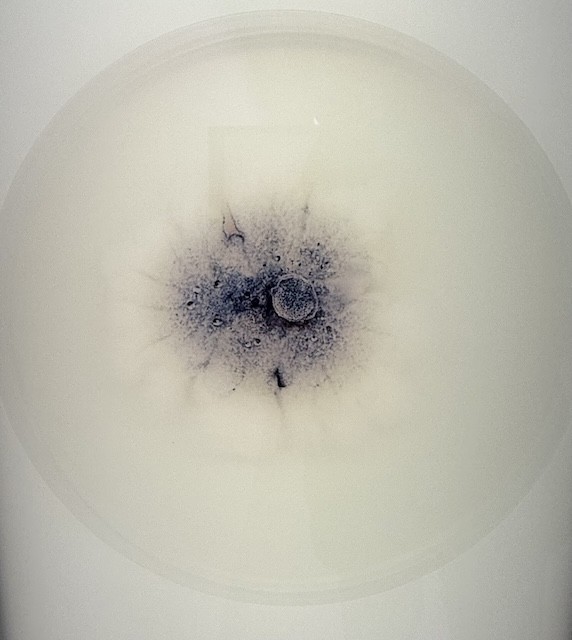
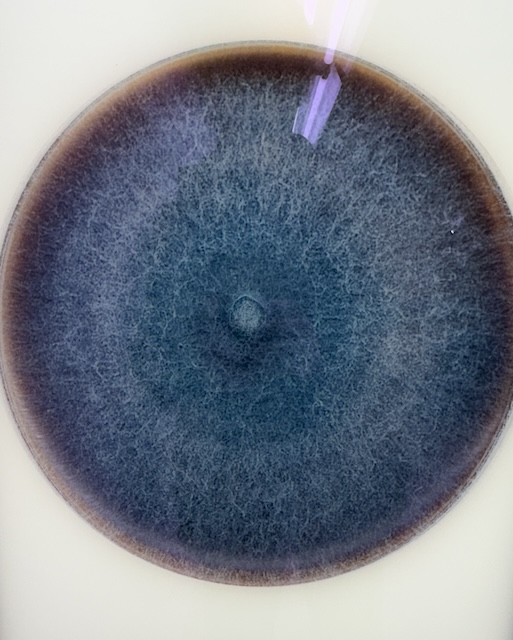

Nos Bons Plans ►
Vacances inter OVS ►
Bienvenue !
Zea30Liveramp22
Spring93
Orelie30
Ruddylejardin
Kdodk
WildCody
NicoBreps78
LoloFrancis
Chacoute971
Pour démarrer le diaporama, clique sur une photo.
Date |
Sortie |
Inscrits |
Organisateur |
||||
| Nicolai howalt | 1 | Pjrock77 |
 Sois le premier à poster un commentaire sur cette sortie !
Sois le premier à poster un commentaire sur cette sortie ! » Je m'inscris «

Tête bleue
Tête bleue Bronze
Bronze Argent
Argent Or
Or Platine
Platine Titane
Titane